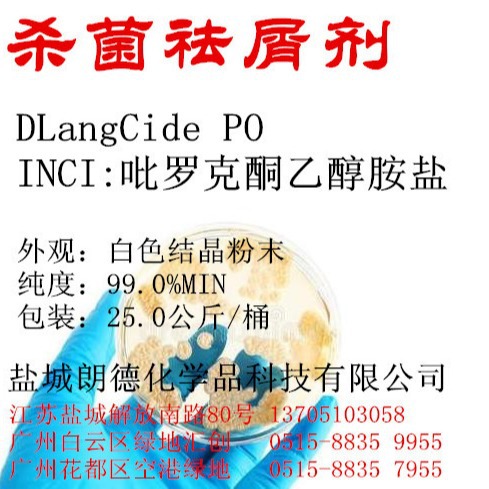

1688工业品为您提供在线免费查询更多化工中间体详细参数、实时报价、规格一览表。更多关于化工中间体多少钱一千克/化工中间体报价明细/化工中间体规格型号价格表/化工中间体批发市场价格/化工中间体官方报价等咨询,尽在1688工业品。询底价>
为你找到合成材料中间体相关产品

二苯基二羟基硅烷 二苯基硅二醇 947-42-2 含量98% 1kg 25kg

湖北武汉
在线询价

S-1-羟基-3-羟基吡咯烷 101385-90-4 有机合成中间体
江苏南通
在线询价

二苯基-2-吡啶膦 有机膦类 37943-90-1 厂家直销 HC 医药中间体
河南濮阳
在线询价

七甘醇单甲醚 4437-01-8 有机化工原料 合成中间体
湖北武汉
在线询价

蝶化三氟乙酸甲酯(TFAM) 431-47-0 98% 工业级 可分装
湖北武汉
在线询价

3,3'-(氧基双亚甲基)双(3-乙基)氧杂环丁烷 18934-00-4
江苏南通
在线询价

MY8866 耐磨防粘防污抗涂鸦助剂 双醇羟基单封端长链烷基硅油
安徽蚌埠
在线询价

日本东芝TSF484高含氢硅油/硅胶抗黄剂
广东深圳
在线询价
OCT 吡罗克酮乙醇胺盐
江苏盐城
在线询价

双十八烷基二甲基氯化铵 玖丰隆供应 cas号107-64-2
湖北武汉
在线询价

四甲基二氢二硅氧烷 3277-26-7 99% 1kg 1吨

湖北武汉
在线询价

N-甲基氨基甲酸甲酯 15年生产经验多用途工厂直供山东福建
山东济南
在线询价
查看更多产品及报价
100+合成材料中间体相关产品等你解锁
在线寻源3000行家正在找货
免费询价,源头正品,上1688工业品,全国的工业正品交易平台




